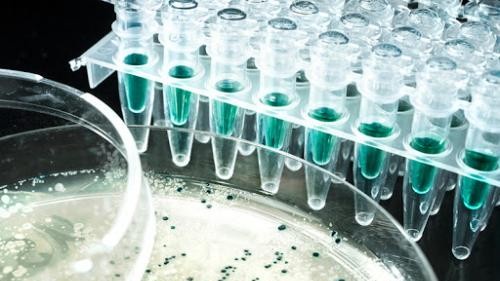

Всемирный банк принял решение о выделении кредита Международной ассоциации развития в 50 млн долларов США на финансирование проекта по модернизации национальной инновационной системы Узбекистана. Проект реализуют в 2021-2026 годы, при этом кредит выделен сроком на 30 лет с льготным 5-летним периодом.
В рамках отдельного соглашения между Республикой Узбекистан и Всемирным банком на создание группы реализации проекта, предоставление необходимого оборудования и помещений и привлечение иностранных консультантов выделен заем в эквиваленте 1924 тыс. долл. США.
Министерство инновационного развития является ответственным за координацию своевременной реализации проекта, а также за целевое и эффективное использование кредитов Международной ассоциации развития.
Кредитные средства направят на финансирование приоритетных проектов: по развитию биотехнологий, повышению плодородия почв, внедрению искусственного интеллекта, развитию возобновляемых источников энергии.
Погашение долга, процентов и обслуживание кредита МАР производятся за счет республиканского бюджета Республики Узбекистан.
По проекту «Модернизация национальной инновационной системы Узбекистана» утверждены:
- основные параметры проекта;
- схема использования средств проекта;
- прогнозный график погашения задолженности, процентов и услуг, и выплаты за посредничество по обязательствам, выделенным Международной ассоциацией развития.
Документ опубликован на государственном языке в Национальной базе данных законодательства и вступил в силу 3 апреля 2021 года, сообщает Norma.